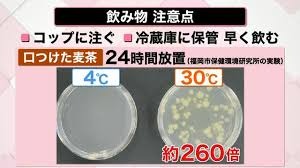

△▼気を付けて!▼△ ~緒方講座・食中毒編~
アップル🍎昭和橋通店のブログ💻をご覧の皆様
ごきげんよう~(*^▽^*)ノオヒサシブリンコ🎵
早々とお盆休みも明けましたが
残暑もまだまだ厳しい日が続きそうです
コロナ感染者の勢いも止まらず劣らず
働く主婦には大打撃👊💣
なぜかって??
それは
コロナが流行りだしてから
多くの方々が経験して来られたであろう
休園・休校
自宅待機にテレワーク
雁字搦めの生活強いられ
子にも親にも自由なんてありゃしない:;(∩´﹏`∩);:
我が子も保育園年少さんでありながら
有難いことに学生で言う夏休み期間でも
お給食が
出るよねぇ~~~~( *´艸`) キャッ
母は当然
楽よねぇ~~~~(´∀`*)ウフフ
とか余裕のよっちゃんでおった矢先
『給食担当職員から
コロナ感染者が出ました』
との連絡
入るよねぇ~~~~( ˘•ω•˘ ) モシカシテ…
勿の論で弁当持参命令
くるよねぇ~~~~_( _´ω`)_メンドイワー
もぉ、
「保育園開園の1食昼寝付きコース」
※今時期のみ昼寝付きなので我が子の帰宅時不機嫌さは皆無
この有難みが
どんだけ身に染みたかッッ!!!!!!
家でお盆時期に先祖に拝むのと当時に
保育所の先生方にも合掌・・・

(※画像はネットより引用+アレンジ)
ナンマンダブナンマンダブ…
(南無阿弥陀仏南無阿弥陀仏)
この時期の弁当持参って正直言って
物凄く気を遣うんですよねぇ~・・・
ひとえに『おにぎり🍙』と言っても
石鹸でしっかり手洗いしてから素手で握るのと
ラップで包みこんで握るのと
これまた雲泥の差ッッ!!!!!!!!
はい、下記の
緒方資料集を見てご覧なさい!!(。-`ω-)ノビシッ

(※画像はネットより引用)

(※画像はネットより引用)

(※画像はネットより引用)

(※画像はネットより引用)
これら
後のアップル🍎昭和橋通店
突撃どきゅんテストに出るからねぇ~
皆メモしといてねぇ~( ..)φカキカキ
先日ニュースにもなりましたが
手作りのおにぎりを食べた14人の子どもが救急搬送
原因は食中毒💀
しかも
朝手作りした際もラップで握ったとの事
しかし
保存法が保冷バッグ等を使用しておらず
だとすると
保存方法がいけなかったのか・・・
怖いですねぇ~~(;´・ω・)
プラスαで
生き物に必須となる水分である飲み物
こちらに関しても侮れませんからねッッ!!??
さぁ~てさてさて
ここで
一撃必殺ダイナマイトクイズ💣
ダダン🎶
次のうちのペットボトル飲料で
直接、口をつけて飲んだ後
細菌がもっとも繫殖しやすい飲み物は
いったいどれでしょ~~~~か??
① 麦茶🌾
② 緑茶🍵
③ オレンジジュース🍊
④ スポーツドリンク🥤
ちっ・・・
ちっ・・・
ちっ・・・
ちー-------んっっっっ
はい、時間切れー----ッッッッ✘✘✘
正解は・・・
さっ……
と、見せかけて
『①』の🌾麦茶🌾なりぃ~~~~(・´з`・)
こちらも参考の資料をご覧ください

(※画像はネットより引用)
(※画像はネットより引用)

(※画像はネットより引用)
スポーツドリンクの資料はここには掲載されておりませんが
以前、わたくしめが確認したところ
繁殖率は麦茶ほどではありませんでした
どうでしたか??
意外や意外(*_*;
こんな暑い中
ペットボトルで一気飲みしたくなる
そんなお気持ち察しますが
口を付けてそのまま一晩、、、
からの翌日また同じものを飲む
な~んて事
あ・り・ま・せ・ん・か????
そんなあなたのお腹の中
細菌だらけですよ💀
気を付けて下さい!!
因みに、我が店舗の中﨑氏は
たとえ緒方がラップで握ったり

(※画像はネットより引用)
百均グッズのおにぎり容器で握ったとしても

(※画像はネットより引用)
食べてくれませんからッッッッ!!!!!!!!
;つД`)カナシィ
「こんな細菌まみれのもん
食えるかッッッッ!!!!!!」
「おんどりゃー-----ッッッッ!!!!!!」

(※画像はネットより引用)
って言われちゃいます
勿論!
緒方だけではなく
店舗マネージャーの梅原氏が
💓愛情込めて💓握ってもNGらしいです、はい。
ってなわけで!!
本日も最後までお付き合いいただき
ありがとうございました(^v^)
クイズ形式のブログもお楽しみ頂けましたでしょうか?
これからも緒方は
皆様の暮らしに笑いと涙と感動感激を与える為
日々精進して行きますゆえ
宜しくお願い致しまぁ~す( ´Д`)ノ~バイバイ
愛知県名古屋市中川区の車買取・新車・新古車・中古車販売
アップル昭和橋通店
052-363-7811
営業時間:10:00~19:00
定休日:水曜日
---------------------------------------------------------------------------------------------------
アップル昭和橋通店は、こんな方々にピッタリのお店です!
★今までディーラーさんの下取でしか車を売却したことのない方
★残価設定で新車を購入したけれど、ディーラーさんの下取にご満足されていない方
★ローンが残っているお車のご売却を検討されている方
★車買取店をご利用されたことのない方
★免許返納に伴うお車のご売却を検討されている方
★大切な愛車なのでしっかりとお車を評価してもらいたい方
★カスタムパーツをしっかり評価してもらいたい方
★強引な営業やしつこい営業が苦手で、安心してご売却をされたい方
★車検が切れてしまっているので自宅へ無料出張査定をしてほしい方
ひとつの選択肢として是非当店をご利用ください!
皆様のご来店を心よりお待ちしております!






